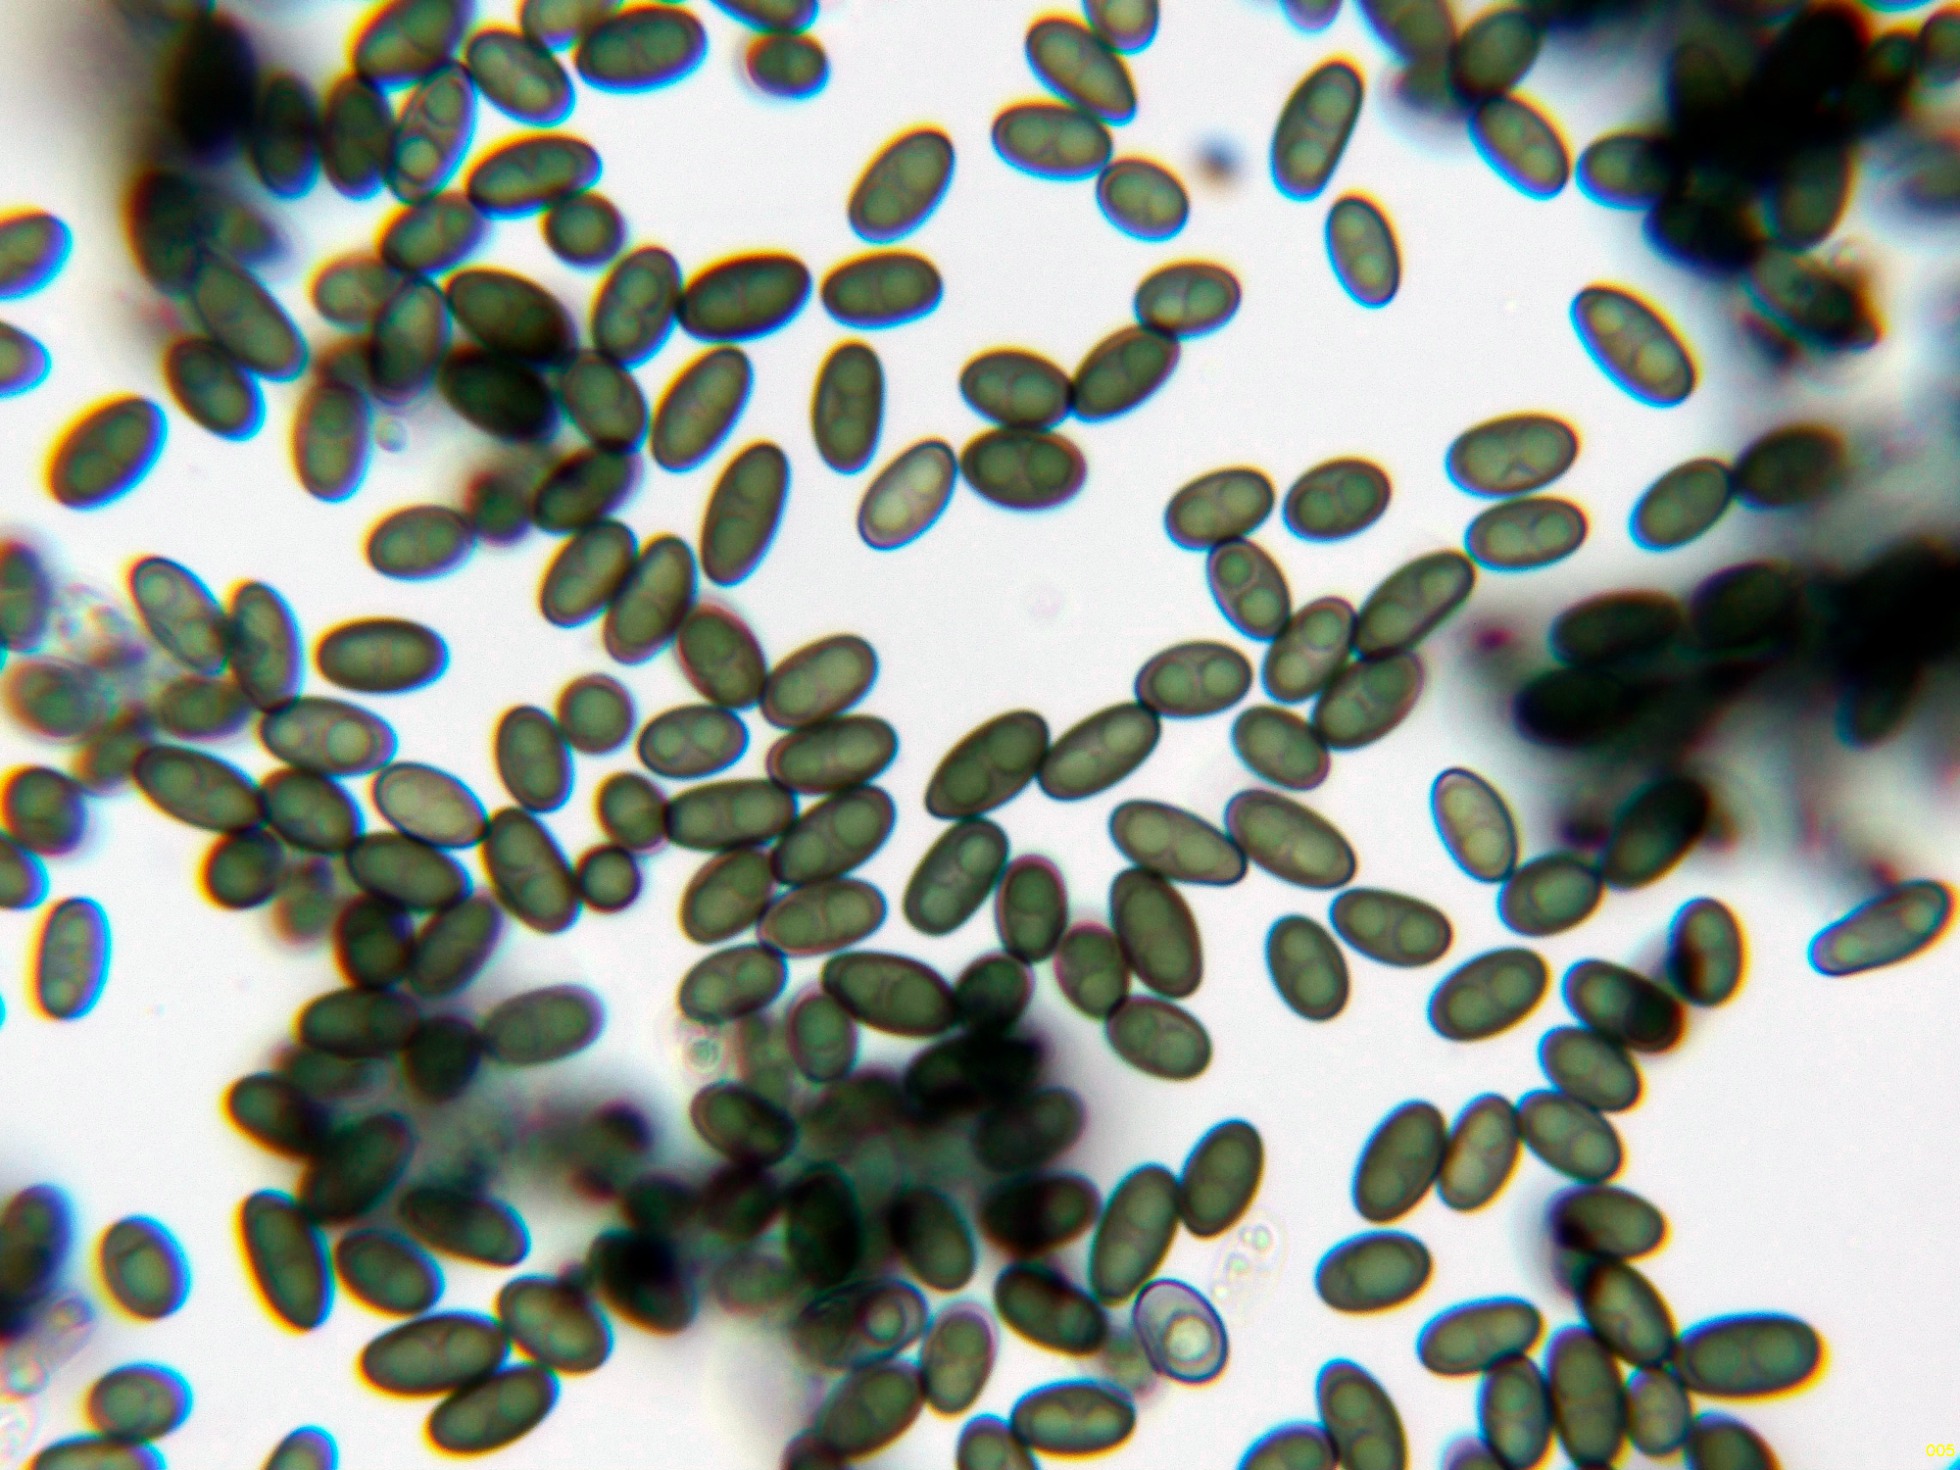

- Foro
- Foros sobre Micología de fungipedia
- Microscopía
- Candanchú 2024: Entonaema cinnabarinum (Cooke & Massee) Lloyd.
 Candanchú 2024: Entonaema cinnabarinum (Cooke & Massee) Lloyd.
Candanchú 2024: Entonaema cinnabarinum (Cooke & Massee) Lloyd.
- Josep Torres
-
 Autor del tema
Autor del tema
- Fuera de línea
- Moderador
-

Menos
Más
- Mensajes: 8746
- Gracias recibidas: 8379
1 año 7 meses antes #110126
por Josep Torres
Hola a tod@s.
Un ascomiceto poco citado, parásito de la Daldinia childiae que presenté anteayer y localizado y fotografiado en el mismo tronco.
Entonaema cinnabarinum (Cooke & Massee) Lloyd
A destacar en su interior, la sustancia gelatinosa y viscosa con fuerte olor a curry.
Una imágen de estudio, con su superficie rojiza que da lugar a su apellido.
Superficie a 20 aumentos:
En la parte exterior se encuentran los peritecios donde están alojados los ascos, la sección a 20 aumentos:
Una ampliación de la sección:
Superficie del ascoma a 40 aumentos:
La sección a 40 aumentos:
Membrana del peridio de los peritecios a 1000 aumentos:
Los ascos en solución de Rojo Congo:
Si bien se indica una reacción amiloide del aparato apical, curiosamente esta reacción no la pude observar utilizando Lugol.
Los ascos en solución de Lugol.
Sin embargo si que pude observar esta reacción utilizando Melzer, algo extraño ya que la concentración de yodo es más baja en el Reactivo de Melzer..
Los ascos con su diminuto aparato apical utilizando el reactivo de Melzer:
Las esporas en solución de Lugol:
Y por último las esporas en agua:
Estas esporas obtenidas por esporulación natural y en agua con unas medidas de:
(8.2) 9 - 10.5 (11.8) × (4.6) 4.8 - 5.48 (5.5) µm
Q = (1.6) 1.7 - 2.1 (2.3) ; N = 40
Me = 9.7 × 5.1 µm ; Qe = 1.9
Esta especie dadas sus características no ofrece confusión alguna.
Saludos a tod@s.
Un ascomiceto poco citado, parásito de la Daldinia childiae que presenté anteayer y localizado y fotografiado en el mismo tronco.
Entonaema cinnabarinum (Cooke & Massee) Lloyd
A destacar en su interior, la sustancia gelatinosa y viscosa con fuerte olor a curry.
Una imágen de estudio, con su superficie rojiza que da lugar a su apellido.
Superficie a 20 aumentos:
En la parte exterior se encuentran los peritecios donde están alojados los ascos, la sección a 20 aumentos:
Una ampliación de la sección:
Superficie del ascoma a 40 aumentos:
La sección a 40 aumentos:
Membrana del peridio de los peritecios a 1000 aumentos:
Los ascos en solución de Rojo Congo:
Si bien se indica una reacción amiloide del aparato apical, curiosamente esta reacción no la pude observar utilizando Lugol.
Los ascos en solución de Lugol.
Sin embargo si que pude observar esta reacción utilizando Melzer, algo extraño ya que la concentración de yodo es más baja en el Reactivo de Melzer..
Los ascos con su diminuto aparato apical utilizando el reactivo de Melzer:
Las esporas en solución de Lugol:
Y por último las esporas en agua:
Estas esporas obtenidas por esporulación natural y en agua con unas medidas de:
(8.2) 9 - 10.5 (11.8) × (4.6) 4.8 - 5.48 (5.5) µm
Q = (1.6) 1.7 - 2.1 (2.3) ; N = 40
Me = 9.7 × 5.1 µm ; Qe = 1.9
Esta especie dadas sus características no ofrece confusión alguna.
Saludos a tod@s.
Adjuntos:
El siguiente usuario dijo gracias: Juan Andrés Román
Por favor, Identificarse para unirse a la conversación.
- Javi Calvo
-

- Fuera de línea
- Spammer
-

Menos
Más
- Mensajes: 7009
- Gracias recibidas: 2955
1 año 7 meses antes #110135
por Javi Calvo
Respuesta de Javi Calvo sobre el tema Candanchú 2024: Entonaema cinnabarinum (Cooke & Massee) Lloyd.
El siguiente usuario dijo gracias: Juan Andrés Román, Josep Torres
Por favor, Identificarse para unirse a la conversación.
- Josep Torres
-
 Autor del tema
Autor del tema
- Fuera de línea
- Moderador
-

Menos
Más
- Mensajes: 8746
- Gracias recibidas: 8379
1 año 7 meses antes #110137
por Josep Torres
Respuesta de Josep Torres sobre el tema Candanchú 2024: Entonaema cinnabarinum (Cooke & Massee) Lloyd.
El siguiente usuario dijo gracias: Juan Andrés Román
Por favor, Identificarse para unirse a la conversación.
- Foro
- Foros sobre Micología de fungipedia
- Microscopía
- Candanchú 2024: Entonaema cinnabarinum (Cooke & Massee) Lloyd.
Tiempo de carga de la página: 0.251 segundos

Foro de micología